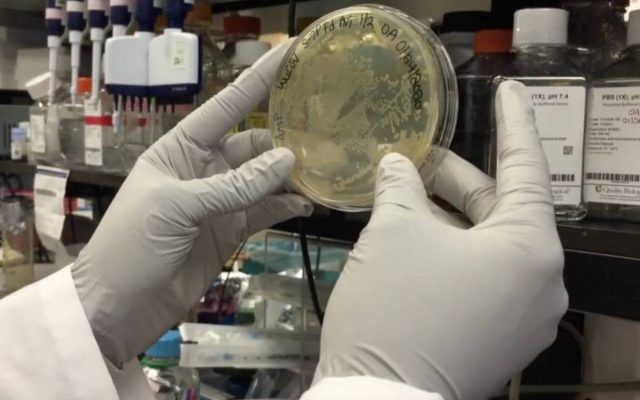

La urgente carrera por encontrar la cura contra el coronavirus
La expansión del coronavirus sigue dejando a su paso gran cantidad de personas infestadas y un número elevado de fallecidos, algo que ha preocupado a todos los países que han reforzado sus protocolos para evitar que la enfermedad llegue o se propague en sus territorios. A esto se suma lo señalado por la Organización Mundial de la Salud (OMS) que elevó el 28 de febrero de “alto” a “muy alto” el riesgo de la epidemia a nivel global.
Debido a la alerta que se ha generado por frenar el avance de este virus mortal, muchas naciones tratan de encontrar un antídoto para acabar con el también conocido COVID-19. ¿Cuánto se ha avanzado en una vacuna contra el coronavirus?
Si bien, hasta el momento se desconoce de alguna cura contra el coronavirus, lo cierto es que los científicos de diversos países se encuentran trabajando por hallar una para frenar su avance y ayudar a quienes ya la padecen.
Al respecto, la OMS informó que se están desarrollando más de 20 vacunas contra el COVID-19 en todo el mundo. Asimismo, existen varias terapias que están en ensayos clínicos.
Fármacos contra el Sida
Es el caso de un tratamiento experimental, basado en uno de los fármacos más utilizados frente al sida desde hace más de una década, ha sido la opción elegida por los facultativos del hospital Virgen del Rocío de Sevilla para tratar con éxito al primer caso de contagio registrado en España del SARS-CoV-2 (Miguel Ángel Benítez, 62 años). Se trata de la aplicación de lopinavir/ritonavir, también usado para prevenir el VIH, junto al interferón beta, una proteína que ayuda a las células a no ser infectadas, según ha publicado EL PAÍS de España.
“Es un tratamiento experimental que ha dado buenos resultados frente a otros virus. Una de sus mayores ventajas es que son fármacos aprobados y utilizados en otras indicaciones, por lo que no hay dudas sobre su seguridad”, señaló Albert Bosch, presidente de la Sociedad Española de Virología.
Los medicamentos utilizados para prevenir el sida serían una combinación perfecta para frenar el COVID-19
Por su parte, Santiago Moreno, jefe de enfermedades infecciosas del Hospital Ramón y Cajal de Madrid explicó que “la combinación de lopinavir y ritonavir inhibe y bloquea al VIH”, por lo que sus resultados frente al coronavirus serían esperanzadores, aunque no se puede determinar con exactitud.
Los buenos resultados obtenidos en el hospital Virgen del Rocío son destacables por la novedad de la Covid-19 y porque aporta una nueva evidencia clínica. Como ocurre en medicina, sin embargo, un solo caso no significa que pueda ser utilizado en otros enfermos ni que el desenlace vaya a ser el mismo. Esa es la misión que cumplen los ensayos clínicos.
Investigación China
En Asia, cada día aparecen al menos 600 casos nuevos de contagiados por el virus. Investigadores de China han trabajado para poder entender la naturaleza del microrganismo que provoca la enfermedad. El último hallazgo que hizo saber este país fue lo realizado en la Universidad de Tianjin, donde aseguran haber sintetizado una vacuna que se administraría de forma oral (en pastilla o aerosol).
El Diario del Pueblo publicó esta noticia, la cual fue replicada en distintos medios de comunicación del mundo. Allí se detalla que la investigación liderada por el académico de la Facultad de Ciencias de la Vida, Huang Jinhai, desarrolló una preparación de control “que utiliza levadura de cerveza (Saccharomyces cerevisiae) como portador, además de llevar una nueva Proteína S – o proteína espiga – de coronavirus con el fin de generar anticuerpos”.
La Universidad de Tianjin asegura haber sintetizado una vacuna que se administraría de forma oral (en pastilla o aerosol).
“Un aspecto requerido para demostrar la seguridad y eficacia de una vacuna corresponde a estudios clínicos”, argumenta Alexis Kalergis, doctor en Microbiología e Inmunología y director del Instituto Milenio de Inmunología e Inmunoterapia (IMII). El desarrollo de esta vacuna en China ha generado suspicacias. “Aparentemente, la vacuna que está desarrollando el grupo de Tianjin no ha sido evaluada en ensayos clínicos. Se debe descartar que la vacuna induzca un fenómeno conocido como exacerbación de enfermedad, el cual podría resultar si se induce una respuesta inflamatoria nociva en el individuo”, agrega Kalergis.
Hallazgo en Texas
La revista Science dio a conocer un estudio realizado por investigadores de la Universidad de Texas que podría ser un avance sustancial para la fabricación de una vacuna en el futuro. “Nuestra publicación describe la estructura atómica de la proteína S, o “espiga”, que este nuevo coronavirus usa para unirse y entrar en las células huésped, de modo que pueda comenzar el proceso de replicación e infección”, detalla Daniel Wrapp, uno de los científicos que estuvo a cargo de dicha investigación. En el estudio, el equipo liderado por Jason McLellan logró realizar un mapa en tres dimensiones de dicha proteína.
Luego de su publicación, Wrapp asegura que «varios investigadores en China se comunicaron con nosotros para solicitarnos detalles sobre nuestra estructura, o los reactivos que se utilizaron durante nuestros estudios experimentales”. Debido a la importancia de este brote, el equipo de Texas tiene la impresión de que Covid-19 se ha convertido en un área de investigación extremadamente activa, particularmente en China.
El equipo de Texas tiene la impresión de que Covid-19 se ha convertido en un área de investigación extremadamente activa, particularmente en China.
El estudio realizado en Texas es un paso importante para encontrar una vacuna, pero no el definitivo. “Al parecer todo apunta a que esta proteína es la clave, pero hay muchos pasos que realizar a posterior. Eso también me hace dudar un poco del anuncio de China”, afirma la doctora Benítez. Para que una vacuna pueda salir a la población debe pasar por varias fases de ensayos clínicos, que implica testear la vacuna en animales, pacientes sanos y pacientes enfermos. Todo esto podría tardar al menos un año.
Inyección Corona Aviar
Científicos israelíes del Instituto Migal desarrollaron una vacuna que podría acabar con el coronavirus “en unas semanas”. De acuerdo con el CEO de dicho centro, David Zigdon, esta podría ser administrada por vía oral.
De validarse este medicamento contra el COVID-19, tendría que pasar un proceso regulatorio de al menos 90 días antes de ser puesta a disposición del público, lo cual implica pruebas clínicas y producción a escala masiva, publica Infobae.
“Estamos en el medio del proceso y esperamos tener la vacuna en nuestras manos en unas semanas. Si todo sale bien, tendríamos una vacuna para prevenir el coronavirus. Estamos en medio de discusiones intensas con potenciales socios que nos puedan ayudar a acelerar la fase de pruebas en humanos y la concreción del producto final y el proceso regulatorio”, manifestó Zigdon.
Osfato de Cloroquina
Un estudio realizado por un grupo de científicos chinos determinó que el fosfato de cloromina tendría resultados favorables para el tratamiento de la neumonía por coronavirus. Cabe precisar que este elemento tiene estrecha relación directa con el árbol de la quina.
De acuerdo con los resultados, este podría inhibir la exacerbación de la neumonía y acortar el curso de la enfermedad, debido a sus propiedades medicinales.
Los científicos realizaron un análisis clínico y lo recomendaron para que sea incluido en la próxima versión de directrices de prevención, diagnóstico y tratamiento de la neumonía por coronavirus. El estudio fue publicado en la revista BioSciencie Trends.
Solo en los últimos siete días, 30 países sumaron casos de coronavirus. La enfermedad, bautizada Covid-19 se esparce sin control alrededor del planeta.
Los siguientes pasos
Para tratar de encontrar una cura efectiva contra el Covid-19, probablemente los científicos se centrarán en el descubrimiento y el aislamiento de anticuerpos terapéuticos o moléculas pequeñas que sean capaces de neutralizar el virus. Los investigadores de Texas continuarán con su hallazgo, y buscarán saber si la proteína S que pudieron mapear sirve como una vacuna eficaz.
En China, las autoridades de ese país declararon que seguirán incentivando la investigación y el desarrollo de vacunas que puedan frenar el nivel de contagio de coronavirus en su población.
RM